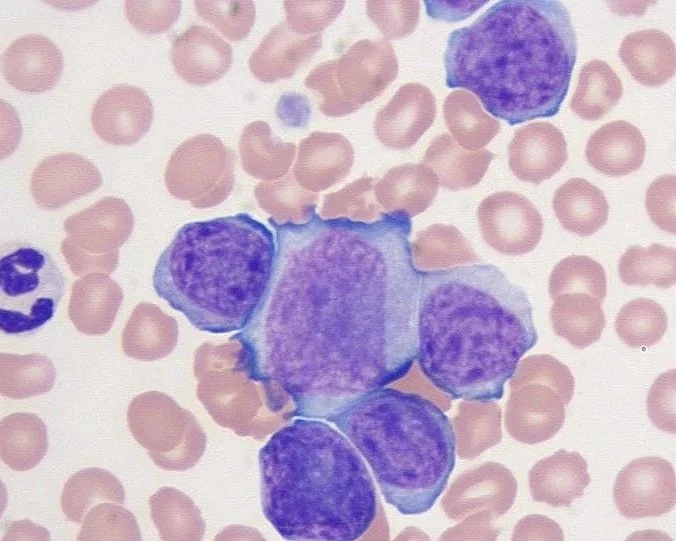

Job openings
Stockholm
-
Onkologi-sköterska
-

Akutsköterska
-

Specialist Internist
We´d love to hear from you…
Vi vill alltid träffa härliga veterinärer och djursjukskötare med fancy titlar.
Har du ingen fancy titel men härlig personlighet och hög kompetensnivå platsar nog också du i teamet.
It´s all about the people…